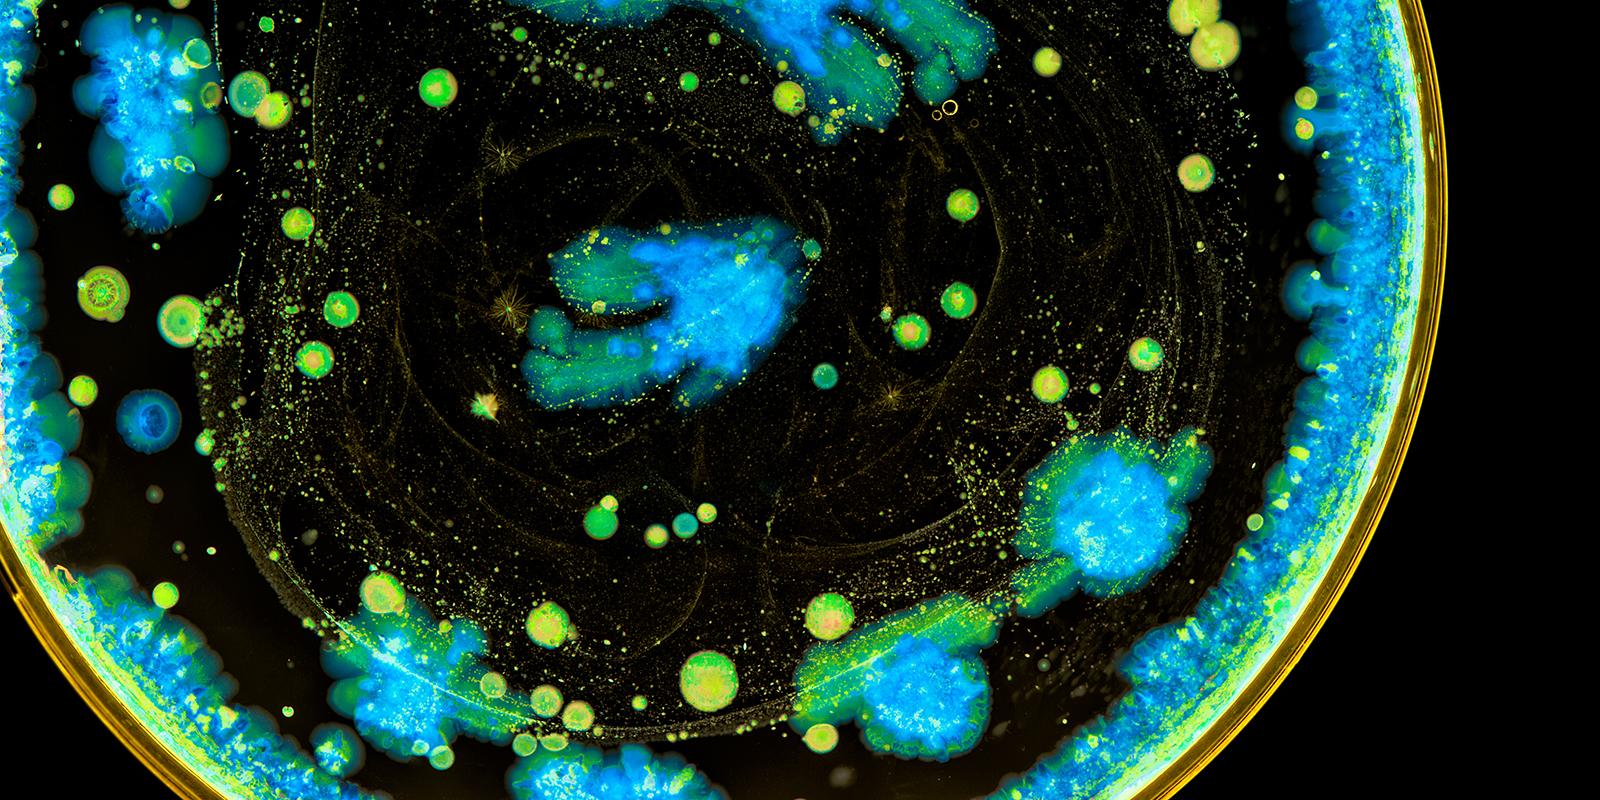

Mintz Advises Spero Therapeutics on Collaboration

Key Facts
- Mintz previously represented Spero Therapeutics, Inc., a biopharmaceutical company developing treatments for multidrug-resistant bacterial infections, in its IPO and numerous transactions
- Advised Spero on an agreement with Everest Medicines for the development and commercialization of SPR206 and an option to license SPR741, two IV-administered product candidates, in Greater China, South Korea, and certain Southeast Asian countries
- The agreement includes an upfront payment of $2 million, plus milestone payments of up to an additional $59.5 million and royalties, for SPR206
- Spero will also receive a $1 million upfront fee for an exclusive 12-month option to the rights to SPR741
The Situation
Spero Therapeutics, Inc. is a multi-asset, clinical-stage biopharmaceutical company focused on identifying, developing, and commercializing novel treatments for multidrug-resistant bacterial infections. Mintz previously advised Spero on its initial public offering (IPO), follow-on offerings, and numerous license and collaboration transactions.
Mintz recently worked with Spero on agreements related to SPR206 and SPR741, two intravenous (IV)-administered product candidates from its Potentiator Platform being developed as innovative options to treat MDR Gram-negative bacterial infections.
The Approach
Mintz advised Spero on the company’s agreement with Everest Medicines to collaborate on the development, manufacture, and commercialization of Spero’s compound SPR206 in Greater China, South Korea, and certain Southeast Asian countries (the “Territory”), along with an exclusive option to license SPR741 in the Territory.
The Mintz team for this most recent transaction was led by Lewis Geffen and included Matthew Gardella, Matthew Tikonoff, Brian Shea, and Scott Pinarchick.
The Outcome
Under the collaboration agreement, Spero will receive an upfront payment of $2 million and is eligible to receive milestone payments of up to an additional $59.5 million upon achievement of specified clinical, regulatory, and commercial milestones related to SPR206, of which Spero anticipates receiving at least $2 million in near-term milestones during 2019. Furthermore, Spero will be eligible to receive high single-digit to low double-digit royalties on any sales of SPR206 products in the Territory following regulatory approval. Everest will also pay Spero a $1 million upfront fee for its exclusive 12-month option to rights to SPR741.



